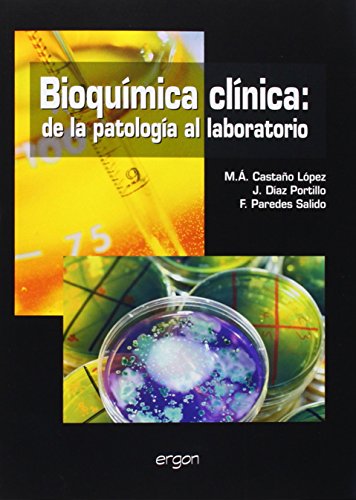
Bioquimica clinica: de la patologia al laboratorio Bioquimica clinica: de la patologia al laboratorio

Descargar Bioquimica clinica: de la patologia al laboratorio Libro PDF
por M.A. Castaño
Click Here to Download (Server 2)
Click Here to Download (Server 3)
Título : Bioquimica clinica: de la patologia al laboratorio
Autor : M.A. Castaño
Format : PDF,ePub,eBook

